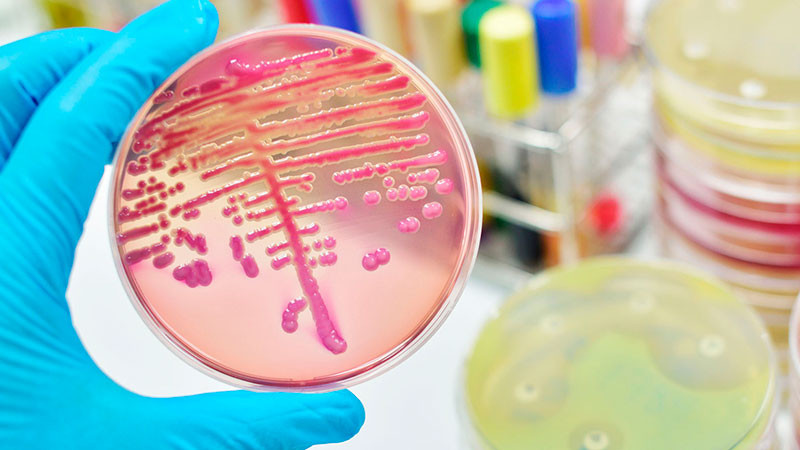
Detecta SSA brote de bacteria en hospitales mexiquenses; emite alerta epidemiológica

Toluca, Estado de México, a 3 de diciembre de 2024.- La Secretaría de Salud emitió una alerta epidemiológica por brote de Klebsiella oxytoca, bacteria causante de infecciones en vías urinarias, neumonías, sepsis, piel y tejidos blandos.
Esto luego que se detectara en el Estado de México 15 casos de Klebsiella oxytoca en hospitales públicos y privados. Los pacientes infectados son menores de edad, entre 0 y 14 años de edad, siendo los neonatos los de mayor vulnerabilidad.
Según la alerta sanitaria, la mayoría de los casos están relacionados con la administración de líquidos de nutrición parenteral, lo que sugiere una infección nosocomial por contaminación en insumos médicos.
Algunos de los síntomas son: alteraciones en la temperatura corporal, taquicardia, choque séptico, elevación de proteína C reactiva, alteración en los glóbulos blancos.
Como medidas de contención, la dependencia federal instó a las unidades médicas a extremar precauciones, sobre todo en el manejo de insumos relacionados con la nutrición parental